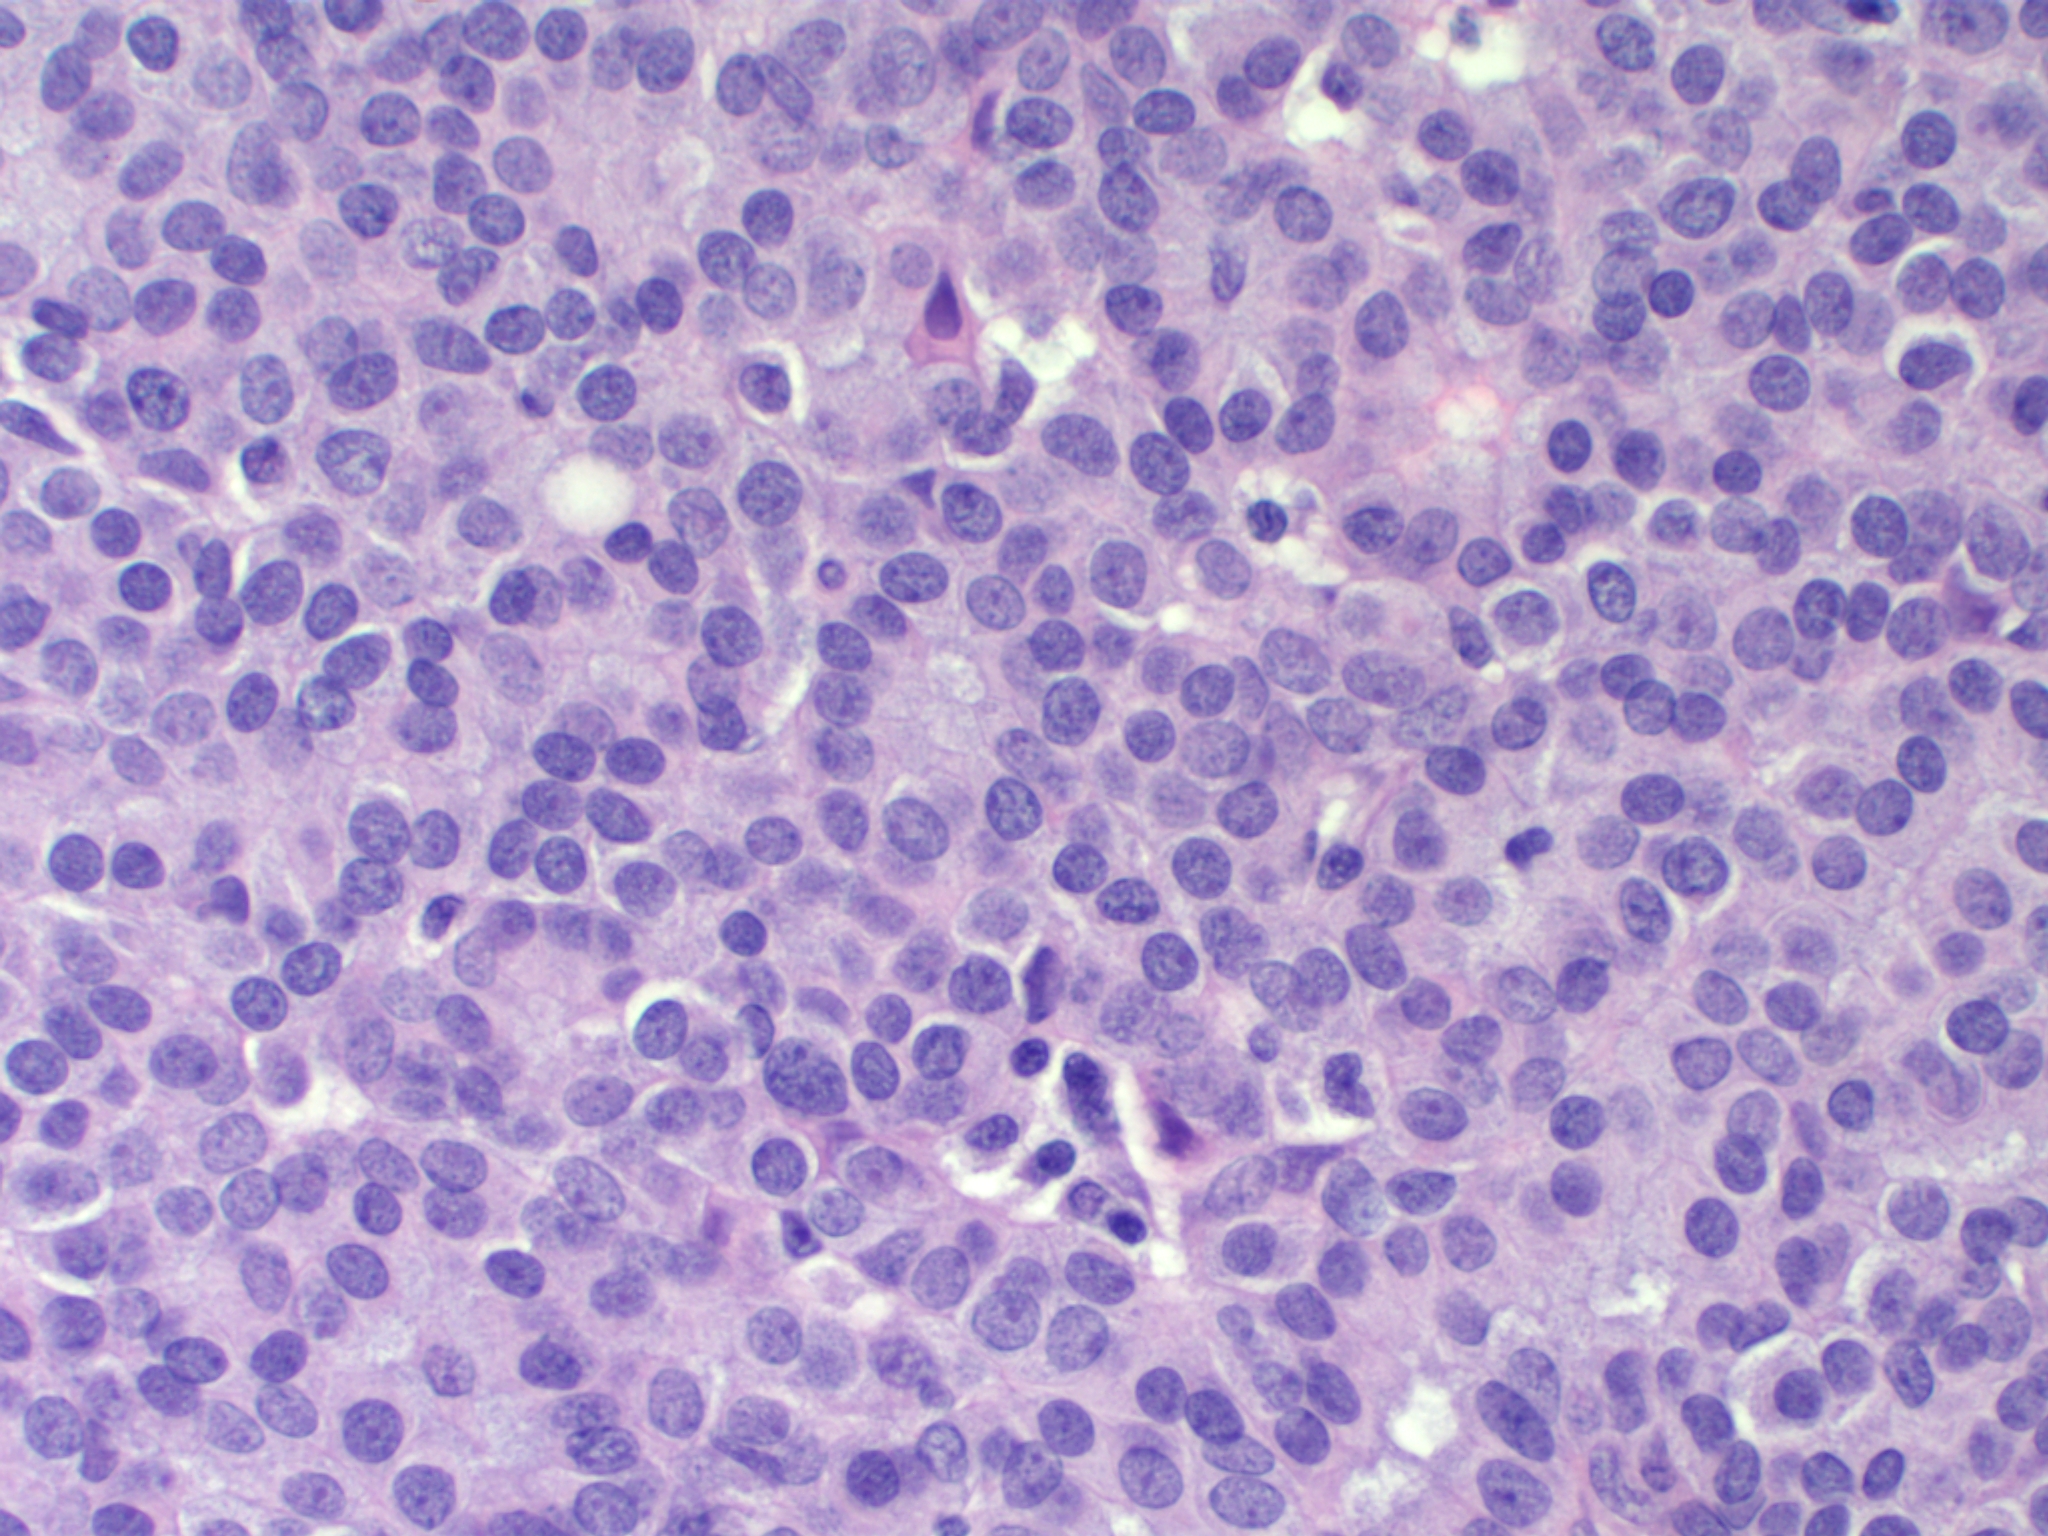

유방유두종
"오늘의AI위키"의 AI를 통해 더욱 풍부하고 폭넓은 지식 경험을 누리세요.
1. 개요
유방유두종은 유방 유관 내에 발생하는 유두상 암종의 일종으로, 관내 유두상 암종(PDCIS), 포낭 내 유두상 암종(EPC), 고형 유두상 암종(SPC), 침윤성 유두상 암종(IPC)의 네 가지 주요 유형으로 분류된다. PDCIS는 비침윤성 암종으로, 주로 폐경기 여성에게서 발견되며, 수술적 제거를 통해 관리된다. EPC는 섬유성 피막으로 둘러싸인 낭 내에서 발생하며, 수술적 절제술이 일반적인 치료법이고 예후가 좋다. SPC는 고형의 세포 덩어리를 형성하며, 유방 보존 수술 또는 유방 절제술로 치료하며, 대부분 예후가 좋다. IPC는 유관을 벗어나 주변 조직으로 침범하는 암종으로, 수술, 방사선 치료, 화학 요법, 호르몬 요법 등을 병행하여 치료한다. 각 유형별로 조직병리학적 특징과 면역조직화학적 특성이 다르며, 치료 방법과 예후도 차이가 있다.
더 읽어볼만한 페이지
- 암종 - 기저세포암
기저세포암은 햇빛 노출 부위에 주로 발생하는 가장 흔한 피부암으로, 윤기 있는 결절이나 붉은 반점 형태로 나타나며, 기저 세포 증식으로 발생하지만 전이가 드물고 다양한 치료법이 존재한다. - 암종 - 이행세포암종
이행세포암종은 이행상피세포에서 기원하는 악성 종양으로, 흡연, 특정 화학 물질, 방사선 노출 등이 위험 요인이며, 혈뇨를 유발하고, 외과적 절제술, 화학 요법, 면역 요법 등으로 치료하며, 유전체 이상이 발병에 관여한다. - 유방암 - BRCA1
BRCA1은 DNA 복구, 전사 조절, 세포 주기 조절 등 다양한 기능을 수행하며 유방암 및 난소암과 관련되어, 이 유전자의 돌연변이는 유전성 유방-난소암 증후군을 유발하여 암 위험을 증가시킨다. - 유방암 - 염증성 유방암
염증성 유방암은 유방이 붓고 붉게 변하는 진행성 유방암의 희귀한 형태로, 종괴가 잘 만져지지 않으며, 영상 검사 및 생검을 통해 진단하고, 수술 전 전신 치료와 방사선 치료를 병행하며, 공격적인 특성으로 다학제적 진료 및 임상 시험 참여가 권장된다. - 희귀암 - 중피종
중피종은 석면 노출이 주요 원인이며 20~50년의 잠복기를 거쳐 흉막, 복막 등에서 발생하는 악성 종양으로, 진단은 영상 검사 등을 통해 이루어지고 수술, 항암 치료 등을 병행하며 예후는 좋지 않다. - 희귀암 - 성인 T세포 백혈병
성인 T세포 백혈병은 사람 T세포 림프친화 바이러스 1형에 의해 유발되는 고위험성 비호지킨 림프종의 일종으로, 고칼슘혈증, 피부 질환, 용해성 골병변 등의 증상을 동반하며 급성형, 림프종형, 만성형, 연성형으로 분류된다.
2. 유두상 유방암의 종류
유두상 유방암은 현미경으로 관찰되는 세포 및 조직의 모양(현미경적 소견), 암세포가 주변 조직으로 퍼져나갔는지 여부(침윤 여부), 그리고 암세포의 유전적 또는 분자적 특징(분자생물학적 특징) 등 다양한 기준에 따라 여러 종류로 분류된다. 주요 유두상 유방암의 종류는 다음과 같으며, 각 종류에 대한 자세한 설명은 해당 하위 섹션에서 다룬다.
- 관내 유두상 암종 (PDCIS)
- 포낭 내 유두상 암종 (EPC)
- 고형 유두상 암종 (SPC)
- 침윤성 유두상 암종 (IPC)
2. 1. 관내 유두상 암종 (Papillary ductal carcinoma in situ, PDCIS)
관내 유두상 암종(PDCIS)은 유방의 유관 내에 국한되어 발생하는 비침윤성 유두상 암종의 한 종류이다. 2012년까지는 낭내 유두상 암종(EPC)과 동일한 질환으로 간주되었기 때문에, PDCIS 자체의 발생 빈도나 임상적 특징에 대한 구체적인 정보는 제한적이다.[3]PDCIS는 주로 폐경기 여성에게서 발견되며, 일반적으로 크기가 작고 특별한 증상이 없는 경우가 많다. 정기적인 유방 촬영술 검사에서 미세 석회화(만져지지 않을 정도로 작은 칼슘 침착물)나 결절 형태의 음영으로 우연히 발견되는 경우가 흔하다.[4] 드물게 혈액이 섞인 유두 분비물이 나타나기도 한다.[11]
남성에게도 PDCIS가 발생할 수 있다. 한 기관의 검토 결과에 따르면, 19세에서 88세 사이의 남성 51명이 PDCIS 진단을 받았으며, 이 중 2명은 여유증(여성형 유방)을 동반하고 있었다.[12] PDCIS는 남성에게 진단되는 상피내관암종 중 가장 흔한 유형으로 알려져 있다.[3] PDCIS 종양은 다른 유형의 (비유두상) 상피내관암종[7]이나 낭내 유두상 암종(EPC)[13]과 함께 나타나기도 한다.
2. 2. 포낭 내 유두상 암종 (Encapsulated papillary carcinoma, EPC)
EPC는 이전에는 PDCIS와 함께 내낭성 유두상 암종으로 분류되었으며,[3] 주로 폐경기 여성에게서 발생한다.[7] 한 대규모 연구에서 EPC 진단을 받은 개인의 연령은 30세에서 93세(중앙값 69세)였으며, 사례의 2%는 남성에게서 진단되었다.[15] 다른 대규모 기관 검토에서는 55세에서 82세 사이의 남성 14명이 EPC를 앓고 있는 것으로 기록되었다.[12]EPC는 일반적으로 작고(예: 0.3cm~9cm[15]), 유륜(유두를 둘러싼 색소 침착 부위) 아래에서 촉진되는 덩어리로 나타난다.[2][3] 나타날 때 5~20%는 유두 분비물이 있으며, 이는 혈액성일 수 있다.[5] 초음파 검사는 일반적으로 낭성 성분이 있을 수 있는 둥근 또는 타원형의 경계가 명확한 덩어리를 감지한다.[3][7] 최근에는 EPC 종양이 정기적인 유방 촬영술 검사에서 처음 발견된 무증상 덩어리로 여성에게서 더 자주 나타난다.[13]
드문 경우, ''상피내'' 또는 침윤성 EPC로 보이는 증상으로 나타난 개인에게서 추가 검사 결과 인접한 겨드랑이의 감시 림프절, 기타 겨드랑이 림프절 및/또는 원격 조직에서 전이가 발견되기도 한다.[2]
2. 3. 고형 유두상 암종 (Solid-papillary carcinoma, SPC)
고형 유두상 암종(SPC)은 보통 가장 넓은 지름이 0.1cm에서 1.5cm 사이인 하나의 종양으로 나타나지만, 드물게 여러 개의 종양이 동시에 발견되기도 한다.[20] 대규모 연구 결과에 따르면, 이 종양은 주로 44세에서 80세 사이의 중년 여성에게서 발생하며,[21] 드물지만 41세에서 88세 사이의 남성에게서도 나타날 수 있다.[12] 발표된 사례들을 검토한 결과, 고형 유두상 암종 환자 중 약 5.8%는 30세 정도의 폐경 전 여성에서 진단되었다. 종양은 유방의 유륜 아래쪽이나 그 주변부에서 비슷한 확률로 발생하며, 혈액이 섞인 유두 분비물이 나타나는 경우가 있다.[21]비침습적인 고형 유두상 암종은 유방 촬영술에서 보통 둥글고 경계가 뚜렷하며 잘 구분되는 고형 종괴로 나타난다. 반면, 주변 조직으로 침윤한 경우에는 종괴의 경계가 불규칙하거나 조직 구조의 변형이 관찰될 수 있다.[3] 대부분 유방 조직 안에 머무르지만, 약 3%에서 5%는 주변 림프절로 전이되고, 약 2.8%는 멀리 떨어진 다른 조직으로 전이되기도 한다.[20] 드물게는 고형 유두상 암종 주변에서 특수 유형이 없는 침윤성 암종이 동시에 발견되기도 한다.[3] 수술로 제거한 부위에서 종양이 재발하거나,[8] 폐와 같이 멀리 떨어진 장기로 전이된 사례도 보고된 바 있다.[20]
2. 4. 침윤성 유두상 암종 (Invasive papillary carcinoma, IPC)
1,147명의 침윤성 유두상 암종(IPC) 여성 환자를 대상으로 한 후향적 연구 결과는 다음과 같다.[1]
이 연구에서 원격 조직으로의 전이는 관찰되지 않았다.[1] 또한, 49세에서 88세 사이의 남성 IPC 환자 8명을 대상으로 한 다른 연구에서도 원격 전이는 보고되지 않았다.[12]
IPC 종양은 주로 다음과 같은 경우 처음 발견된다.[1]
- 혈성 유두 분비물
- 만져지는 유방 덩어리
- 유방 촬영술 등 방사선 검사 이상 소견 (둥글거나, 타원형이거나, 엽상 형태의 덩어리)
3. 병리학적 특징
유방 유두종은 조직학적 소견에 따라 여러 아형으로 분류되며, 각 아형은 고유한 병리학적 특징을 통해 감별된다. 이는 진단 및 치료 방침 결정에 중요하다.
- 관내 유두상 암종(PDCIS): 유관 내에 국한된 상피내암으로, 섬유혈관 중심을 가진 유두상 구조가 특징이다.[4] 근상피세포는 유두 구조 주변에는 존재하나 병변이 있는 관 내부에는 없어 다른 아형과 구별된다.[4][7][3]
- 포낭 내 유두상 암종(EPC): 두꺼운 섬유성 캡슐에 완전히 둘러싸인 유두상 구조를 특징으로 하며, 이 캡슐의 존재가 중요한 감별점이다.[6][3] 일반적으로 근상피세포는 관찰되지 않는다.[6] 캡슐 내 국한된 형태와 침윤성 형태로 나뉜다.[3][5]
- 고형 유두상 암종(SPC): 유두 구조보다는 종양 세포가 빽빽한 덩어리(고형 시트)를 이루는 것이 특징이다.[21] 상당수에서 신경내분비 분화 소견을 보이는 것이 중요한 특징이며,[21] 뮤신 함유 반지 모양 세포가 관찰되기도 한다.[10]
- 침윤성 유두상 암종(IPC): 주변 조직으로 침윤하는 유두상 구조를 특징으로 한다.[22] 침윤 부위에는 근상피세포가 없고 섬유성 캡슐이 없는 것이 진단 기준이다.[6][7][20][22]
3. 1. 관내 유두상 암종 (PDCIS)
관내 유두상 암종(Papillary Ductal Carcinoma In Situ, PDCIS)은 유방의 유관 내에서 발생하는 유두상 병변의 한 형태로, 상피내암에 해당한다.현미경적 조직병리학 검사를 통해 진단되며, 특징적인 유두 모양 구조와 세포 배열을 보인다.[4] 이러한 구조는 섬유혈관성 중심을 가지는 잎 모양 돌기와 이를 덮는 신생물성 상피 세포로 이루어진다. 특정 유형의 세포(구형 세포)가 동반되기도 한다.[7][6][3] 근상피세포의 유무는 다른 유두상 병변과의 감별에 중요한 요소이며,[4][7][3] 때때로 죽은 세포가 쌓인 괴사 소견("코메도형 괴사")이 동반될 수 있다.[6]
면역조직화학 검사를 통해 에스트로겐 수용체, 프로게스테론 수용체, HER2/neu 등의 발현 양상을 확인하며, 이는 진단 및 예후 예측에 참고될 수 있다.[14][6][13] PDCIS와 관련된 특정 유전자 변형에 대한 연구도 진행 중이다.[6][4]
3. 1. 1. 조직병리학
전형적인 유두상 관내 상피내 암종(PDCIS) 병변의 현미경적 조직병리학적 특징은 헤마톡실린 및 에오신 염색을 통해 관찰할 수 있다. 병변은 유두 모양의 잎(가늘고 손가락 또는 잎사귀 모양의 구조)이 섬유혈관성 중심(core)을 가지며, 이 잎들이 하나 또는 여러 층의 신생물성 상피세포로 덮여 있는 형태로 나타난다. 상피 세포는 주로 키가 크고 폭이 좁은 원주 모양이며, 세포 핵은 관 부착 부위 가까이에 위치한다.[4] 잎의 표면을 덮는 상피 세포는 일반적으로 고형(solid), 사상(cribriform, 즉 크고 다양한 크기의 둥근 공간으로 관통된 많은 세포 둥지 형태), 또는 미세유두상(micropapillary) 패턴을 보인다.
때로는 일반적인 신생물성 상피 세포 외에, 풍부하고 투명한 세포질을 가진 '구형 세포'(apocrine cell)라는 두 번째 세포 집단이 관찰될 수 있다.[7] 이 세포들은 에오신 염색 시 분홍색 또는 붉은색으로 염색되는 호산성 세포질을 가진다.[6] 이러한 구형 세포가 동반된 PDCIS는 '아포크린 변이형'(apocrine variant)으로 분류되기도 한다.[3]
근상피세포는 일반적으로 유두상 잎의 주변부에는 존재하지만, 병변이 발생한 관 내부에서는 발견되지 않는다.[4][7] 섬유성 피막이 있거나 주변에 근상피세포가 없는 것은 종양이 PDCIS가 아닌 피막 유두상 암종(EPC) 또는 고형 유두상 암종(SPC)임을 시사하는 강력한 지표이다.[3] PDCIS 조직 내에는 죽은 세포들이 쌓여 형성된 "코메도형 괴사" 부위가 관찰될 수도 있다.[6]
면역조직화학 연구 결과, PDCIS 종양 세포는 상당수에서 에스트로겐 수용체(ER)와 프로게스테론 수용체(PR)를 발현하는 경향이 있다. 2009년 54명의 PDCIS 환자를 대상으로 한 연구에서는 각각 34명(63%), 31명(57%)의 종양 세포에서 ER, PR 발현이 확인되었고, 35명(65%)에서는 HER2/neu 단백질 발현이 나타났다.[14] 최근 보고에 따르면 대부분의 PDCIS 종양 세포는 에스트로겐 수용체를 강하게 발현하며,[6] 에스트로겐 수용체를 발현하지 않는 경우는 일반적으로 조직학적으로 더 나쁜 예후를 시사하는 특징을 보인다.[13]
현재까지 PDCIS 종양 세포에서 반복적으로 나타나는 특정 유전자 변형은 확인되지 않았다.[6] 간혹 발견되는 유전자 변형은 저등급 관내 상피내 암종(low-grade DCIS)에서 관찰되는 것과 유사한 양상을 보인다.[4]
3. 2. 포낭 내 유두상 암종 (EPC)

포낭 내 유두상 암종(Encapsulated Papillary Carcinoma, EPC)은 현미경적으로 섬유혈관 중심을 가진 유두상 구조가 낭성 공간 내에서 증식하며, 이 전체가 두꺼운 섬유성 캡슐에 둘러싸인 형태를 특징으로 한다. 일반적으로 신경내분비 분화나 근상피 세포는 관찰되지 않는다.[6]
이 조밀한 섬유 캡슐의 존재는 EPC를 다른 유두상 유방 종양, 특히 유관 상피내 유두상 암종(PDCIS)과 구별하는 중요한 특징이다.[3] 또한 신경내분비 분화나[3] 주변 근상피 세포가 없다는 점[7] 역시 다른 유두상 병변과의 감별에 도움이 된다.
EPC는 섬유 캡슐 내에 완전히 국한된 ''제자리'' 형태와 캡슐을 넘어 주변 조직으로 침윤하는 침윤성 형태로 나뉜다.[3][5] 침윤성 EPC는 드물게 림프절이나 다른 장기로 전이될 수 있다.[6] 때로는 다른 유형의 유방암과 함께 발견되기도 한다.[3][7]
면역조직화학적으로 대부분의 EPC는 에스트로겐 수용체와 프로게스테론 수용체에 양성을 보이며 HER2/neu에는 음성인 경우가 많다.[7][16] 그러나 일부 악성도가 높은 EPC는 삼중 음성 특징을 보이기도 한다.[6] 유전자 분석에서는 특정 염색체의 복제 수 변이나 ''PIK3CA'',[17] ''KMT2A'', ''CREBBP''[6] 등 암 발생과 관련된 유전자의 돌연변이가 발견되기도 한다.[18][19]
3. 2. 1. 조직병리학
포획 유두상 암종(EPC)의 현미경적 조직병리학 소견은 일반적으로 섬유혈관 중심부를 가진 유두상 구조와 낭성 공간 내에서 증식하는 신생물성 상피 세포를 특징으로 한다. 이 모든 구조는 조밀한 섬유 캡슐로 둘러싸여 있다. 일반적으로 EPC 종양에는 신경내분비 변성이나 근상피 세포 부위가 없다.[6]
조밀한 섬유 캡슐의 존재는 EPC를 다른 유두상 유방 종양, 특히 유관 상피내 유두상 암종(PDCIS)과 구별하는 중요한 특징이다.[3] 또한, 신경내분비 분화 부위가 없다는 점은 고형 유두상 암종(SPC)과의 감별에 도움이 되며,[3] 주변에 근상피 세포가 없다는 점은 PDCIS와의 구별에 도움을 준다.[7]
EPC 종양은 섬유 캡슐 내에 완전히 국한되거나(이를 ''제자리'' EPC라고 함), 캡슐을 뚫고 주변 정상 유방 조직이나 흉부 근육으로 침윤하는 부위를 하나 이상 가질 수 있다(이를 침윤성 EPC라고 함).[3][5] 한 연구에서는 EPC 환자 25명 중 14명이 ''제자리'' 질환, 11명이 침윤성 질환을 앓았으며, 침윤성 종양 중 6개는 현미경적 조직병리학 기준으로 고등급 종양으로 평가되었다.[5] 드물게 EPC 종양은 인근의 감시 림프절, 다른 겨드랑이 림프절, 또는 원격 조직으로 전이될 수 있다. 이러한 전이 병변은 일반적으로 원발 종양과 유사한 유두상 형태를 보인다.[6] 또한 드물게 EPC 종양은 인접한 PDCIS,[7] 특별 유형이 없는 침윤성 암종, 침윤성 망상 유방 암종, 점액성 암종, 또는 관상 암종과 함께 발견되기도 한다.[3]
대부분의 EPC 환자 종양 세포에 대한 면역조직화학 염색 결과, 에스트로겐 수용체와 프로게스테론 수용체가 강하게 발현되지만 HER2/neu 단백질은 발현되지 않는 것으로 나타난다.[7] 49건의 EPC 사례를 분석한 연구에서는 47건에서 에스트로겐 및 프로게스테론 수용체가 발현되었고, 단 8건에서만 HER2/neu 단백질이 발현되었다.[16] 그러나 현미경적 조직병리학 분석에서 악성도가 더 높은 것으로 판명된 EPC 종양(전체 사례의 약 5%~10%)은 에스트로겐 수용체, 프로게스테론 수용체, HER2/neu 단백질이 모두 발현되지 않는 삼중 음성인 경우가 많았다.[6]
유전자 분석 연구에 따르면, 일부 환자의 EPC 종양 세포는 염색체 16의 q(즉, 긴) 팔에서 유전 물질 손실, 염색체 16의 p(또는 짧은) 팔에서 유전 물질 획득, 염색체 1의 q 팔에서 유전 물질 획득과 같은 복제 수 변이를 보인다. 또한, EPC 종양에서 ''PIK3CA'' 유전자의 핫 스팟 돌연변이(질병 유발 돌연변이)가 확인되었는데, 이 유전자의 활성화 돌연변이는 유방암 및 다른 암의 발생 및 진행을 촉진할 수 있다.[17] 염색질 리모델링(염색질 구조 변경)과 관련된 두 유전자, 즉 ''KMT2A''와 ''CREBBP''의 재발성 변화도 일부 EPC 사례의 종양 세포에서 확인되었다.[6] 이 두 유전자의 변화 역시 ''PIK3CA'' 유전자 변화와 유사하게 유방암 및 다른 암의 발생 및 진행과 관련이 있다.[18][19]
3. 2. 2. 면역조직화학
대부분의 유방유두종(EPC) 종양 세포는 면역조직화학 검사 결과, 에스트로겐 수용체(ER)와 프로게스테론 수용체(PR)가 강하게 발현되는 양상을 보인다. 반면, HER2/neu 단백질은 발현되지 않는 경우가 많다.[7] 49명의 유방유두종 환자를 대상으로 한 임상병리학적 연구에서는 47명(약 96%)의 종양 세포에서 에스트로겐 수용체와 프로게스테론 수용체가 발현되었으며, HER2/neu 단백질이 발현된 경우는 8명(약 16%)에 불과했다.[16]그러나 조직병리학적으로 악성도가 더 높은 유방유두종(전체 사례의 약 5%~10%)의 경우, 에스트로겐 수용체, 프로게스테론 수용체, HER2/neu 단백질이 모두 발현되지 않는 삼중 음성 특징을 보이는 경우도 있다.[6]
3. 3. 고형 유두상 암종 (SPC)
고형 유두상 암종(Solid Papillary Carcinoma, SPC)은 유방암의 드문 아형 중 하나로, 주로 폐경기 이후 여성에게서 발견된다. 현미경적으로 종양 세포들이 빽빽하게 덩어리(고형, solid)를 이루며 증식하는 패턴을 보이는 것이 특징이며, 일반적인 유두상 암종에서 보이는 명확한 유두 구조는 잘 나타나지 않을 수 있다.SPC는 종종 신경내분비 분화 소견을 보이며,[21] 대부분 에스트로겐 수용체(ER)와 프로게스테론 수용체(PR)를 발현하고 HER2/neu는 발현하지 않는 경향이 있다.[21] 일부에서는 ''PIK3CA'' 유전자 돌연변이 등 특정 유전적 변화가 관찰되기도 한다.[3][20] 이 종양은 상피내암(제자리암) 또는 침윤성 암종의 형태로 나타날 수 있으며, 침윤성인 경우 다른 유형의 침습성 유방암과 동반될 수 있다.[3]
3. 3. 1. 조직병리학

고형 유두상 암종(Solid Papillary Carcinoma, SPC) 병변의 현미경적 조직병리학적 분석 결과, 종양 세포는 일반적으로 방추형(길쭉한 모양) 또는 형질 세포와 유사한 형태를 보인다. 헤마톡실린 및 에오신 염색 시 에오신을 흡수하여 세포질이 붉은색에서 분홍색을 띠며, 핵은 중심에서 벗어나 한쪽으로 치우쳐 있는 경우가 많다. 드물게는 세포핵이 한쪽으로 밀려 반지처럼 보이는 반지 모양 세포가 관찰된다. 종양 내부에는 액체가 찬 주머니(낭성 부위)나 출혈 부위가 있을 수 있으며, 종양 내부와 주변부에서는 근상피 세포가 발견된다. 다른 유두상 병변에서 흔한 유두 구조(papillary structure)는 SPC에서는 잘 나타나지 않는다. 대신, 작은 혈관 주위에 종양 세포가 방사상으로 배열된 가성 로제트(pseudo-rosette)나, 지지 조직인 기질 코어 주위에 핵이 울타리처럼 평행하게 배열된 핵 층상 배열(nuclear palisading)이 관찰될 수 있다.
SPC 종양 조직의 약 50% 이상에서 신경내분비 분화, 즉 신경 세포나 호르몬 분비 세포의 특징을 일부 나타내는 부위가 발견되며, 이는 SPC 진단을 강력하게 뒷받침한다.[21] 또한, 반지 모양 세포는 세포질 내에 뮤신(점액 물질)을 함유한 공포(작은 주머니)를 가지며, 이로 인해 핵이 한쪽으로 밀려난 형태를 보인다.[10] 뮤신은 세포 외부에서도 발견될 수 있으며, 세포 외 뮤신 유무와 관계없이 뮤신 함유 공포를 가진 반지 모양 세포의 존재 역시 SPC 진단의 중요한 근거가 된다.
SPC가 주변 조직으로 침윤할 경우, 종양 세포 덩어리(종양 둥지)의 가장자리가 불규칙하고 톱니 모양처럼 거칠어지는 특징적인 직소(jigsaw) 성장 패턴을 보인다. 이 침윤 부위에서는 정상적으로 존재해야 하는 근상피 세포가 소실된다.[21] 드물게 침습성 SPC는 인접한 비특이적 침윤성 암종(NST), 소엽 암종, 사상 암종 또는 관상 암종과 같은 다른 유형의 침습성 유방암과 함께 발생하기도 한다.[3]
면역조직화학 검사상, 대부분의 SPC 종양 세포는 에스트로겐 수용체와 프로게스테론 수용체를 발현하지만, HER2/neu 단백질은 발현하지 않는 경향이 있다.[21] 유전자 분석 연구에서는 일부 SPC 종양 세포에서 염색체 16번 장완(16q) 또는 단완(16p) 소실, 염색체 1번 장완(1q) 획득, '''PIK3CA''' 유전자 돌연변이(약 40% 사례) 등의 분자적 변화가 확인되었다. 또한, 신경내분비 분화와 관련된 단백질들, 예를 들어 ''RET 원형 암 유전자''에 의해 암호화되는 GDNF 리간드족 단백질, ''ASCL1'' 유전자에 의해 암호화되는 ASCL1 단백질, ''DOK7'' 유전자에 의해 암호화되는 Dok-7 단백질,[3] ''ENOL2'' 유전자에 의해 암호화되는 에놀라제 2, ''SYP'' 유전자에 의해 암호화되는 시냅토피신, 그리고 각각 ''CHGA'' 및 ''CHGB'' 유전자에 의해 암호화되는 크로모그라닌 A 및 크로모그라닌 B의 발현이 관찰되었다.[20]
3. 3. 2. 면역조직화학
면역조직화학적 분석 결과, 대부분의 고형 유두상 암종(SPC) 사례에서 종양 세포는 에스트로겐 수용체(ER)와 프로게스테론 수용체(PR)를 발현하지만, HER2/neu 단백질은 발현하지 않는 것으로 나타났다.[21] 이는 특정 호르몬 요법에 반응할 가능성이 있음을 시사한다.유전자 분석 연구에서는 일부 개인의 SPC 종양 세포에서 다음과 같은 분자적 변화가 발견되었다.
- 염색체 16번 장완(16q) 또는 단완(16p)의 손실
- 염색체 1번 장완(1q)의 획득
- ''PIK3CA'' 유전자 돌연변이 (약 40% 사례)[3]
또한, 신경내분비 분화와 관련된 단백질 발현이 관찰되기도 한다. 여기에는 다음 유전자들에 의해 암호화되는 단백질들이 포함된다.
- ''RET 원형 암 유전자'' (GDNF 리간드족)
- ''ASCL1'' (ASCL1)
- ''DOK7'' (Dok-7)[3]
- ''ENOL2'' (에놀라제 2)
- ''SYP'' (시냅토피신)
- ''CHGA'' (크로모그라닌 A)
- ''CHGB'' (크로모그라닌 B)[20]
이러한 신경내분비 표지자의 발현은 SPC가 신경내분비 종양의 특징을 일부 가질 수 있음을 보여준다.
3. 4. 침윤성 유두상 암종 (IPC)

침윤성 유두상 암종(Invasive Papillary Carcinoma, IPC)은 유방암의 드문 아형 중 하나이다. 초기 연구에서는 침윤성 캡슐화 유두상 암종(EPC)이나 고형 유두상 암종(SPC)과의 구분이 명확하지 않아 일관된 병리학적 데이터 축적이 어려웠다.[7]
현미경적으로 IPC는 섬유 혈관 중심 주위에 종양 세포가 유두 모양으로 배열된 구조를 특징적으로 보이며,[1][4][3] 정의상 주변 유방 조직이나 가슴 근육으로 침윤하는 양상을 보인다.[22] 이러한 침윤 소견은 IPC 진단에 중요한 기준이 된다.[6][7][20][22] 드물게 관상피내암종(DCIS)이 동반되기도 한다.[3]
3. 4. 1. 조직병리학
초기에 발표된 침윤성 유두상 암종(IPC) 사례 중 다수는 침윤성 캡슐화 유두상 암종(EPC) 또는 고형 유두상 암종(SPC)의 변형으로 여겨져, IPC에 대한 일관된 병리학적 데이터를 얻기 어려웠다.[7] IPC의 현미경적 조직병리학 연구에서는 다음과 같은 특징들이 보고되었다(오른쪽 고배율 현미경 사진 참조):
- '''1)''' 섬유 혈관 중심(core)을 둘러싸는 신생물성 상피 세포로 이루어진 뭉툭한 유두 모양 또는 관 모양 구조[1]
- '''2)''' 확장된 관 안에 위치하며, 다양한 크기의 미세 낭종과 괴사 (즉, 죽은 세포) 부위를 동반하는 유두[4]
- '''3)''' 신생물성 상피 세포로 덮인 섬유 혈관 중심이 종양의 대부분을 차지하는 경우[3]
- '''4)''' 종양의 90% 이상이 유두 모양을 보이며 주변 유방 조직 및/또는 유방 아래 가슴 근육으로 침윤하는 양상[22]
연구자들은 IPC 종양이 정의상 인접한 유방 조직이나 근육 조직으로 침윤하는 부위를 최소 한 곳 이상 가지며, 이 침윤 부위에는 근상피 세포가 없고, 일반적으로 주변을 둘러싸는 섬유성 막(캡슐)이 없다는 점에 동의한다. 이러한 특징들은 IPC 진단에 매우 중요하다.[6][7][20][22] 드물게, 관상 피내 암종 병변이 IPC 근처에서 발견되기도 한다.[3]
IPC 진단을 받은 1,147명의 종양 조직을 후향적으로 분석한 결과, 각각 89.3%와 83.4%의 사례에서 에스트로겐 수용체와 프로게스테론 수용체가 발현되었고, HER2/neu 단백질은 2.4%에서 발현되었다(단, 46.4%의 사례는 HER2/neu 검사를 받지 않았다).[1] IPC로 진단된 44명을 대상으로 한 다른 연구에서는 종양 세포에서 에스트로겐 수용체 발현이 72.7%, 프로게스테론 수용체 발현이 72.7%, HER2/Neu 단백질 발현이 13.6%로 나타났다.[22]
IPC로 진단받은 개인의 종양 세포와 관련된 특정 유전적 변이는 아직 명확하게 밝혀지지 않았다.[6]
3. 4. 2. 면역조직화학
침윤성 유두상 암종(IPC) 종양 조직에 대한 면역조직화학적 분석 결과, 호르몬 수용체 발현 양상은 연구에 따라 다소 차이를 보인다.1,147명의 종양 조직을 대상으로 한 대규모 회고적 분석에서는 종양 세포가 에스트로겐 수용체(ER)를 발현하는 경우가 89.3%, 프로게스테론 수용체(PR)를 발현하는 경우가 83.4%로 높게 나타났다. 반면, HER2/neu 단백질 발현율은 2.4%로 낮았으나, 이 연구에서 HER2/neu 검사는 전체 사례의 절반 가량(46.4%)에서만 이루어졌다는 점을 고려해야 한다.[1]
다른 44명의 IPC 진단 환자를 대상으로 한 소규모 연구에서는 에스트로겐 수용체와 프로게스테론 수용체 발현율이 각각 72.7%로 나타났으며, HER2/Neu 단백질 발현율은 13.6%로 보고되었다.[22]
이러한 결과들을 종합해 볼 때, 침윤성 유두상 암종은 대체로 에스트로겐 수용체와 프로게스테론 수용체 양성, HER2/neu 음성인 아형일 가능성이 높지만, 개별 사례에서는 다양한 발현 양상을 보일 수 있다.
4. 유전자 변이
각 유두상 유방암 유형별로 나타나는 유전자 변이는 다음과 같다.
- 유두상 관내 상피내 암종 (PDCIS): 종양 세포에서 반복적으로 발견되는 특정 유전자 변이는 아직 확인되지 않았다.[6] 다만, 일부 사례에서 발견된 변이는 저등급 관내 상피내 암종에서 나타나는 변이와 유사한 경향을 보였다.[4]
- 피막 유두상 암종 (EPC): 유전자 분석 연구에 따르면, 일부 EPC 환자의 종양 세포에서는 염색체 16번의 긴 팔(16q) 유전 물질 손실, 16번 염색체의 짧은 팔(16p) 유전 물질 획득, 염색체 1번의 긴 팔(1q) 유전 물질 획득과 같은 복제 수 변이가 관찰된다. 또한, 암의 발달 및 진행을 촉진할 수 있는 ''PIK3CA'' 유전자의 특정 부위 돌연변이(핫스팟 돌연변이)가 확인되었다.[17] 염색질 리모델링과 관련된 유전자인 ''KMT2A''와 ''CREBBP''의 재발성 변화도 일부 EPC 사례에서 발견되었다.[6] 이들 유전자의 변화는 ''PIK3CA'' 유전자 변이와 마찬가지로 유방암 및 다른 암의 발달 및 진행과 관련이 있는 것으로 알려져 있다.[18][19]
- 고형 유두상 암종 (SPC): 일부 SPC 환자의 종양 세포에서도 분자적 변화가 발견되었다. 여기에는 염색체 16q 장완의 손실, 염색체 16 단완의 손실, 염색체 1 장완의 획득 등이 포함된다. 또한, 약 40%의 사례에서 PIK3CA 유전자 돌연변이가 관찰되었다. 신경내분비 분화와 관련된 단백질들의 유전자 발현 변화도 나타나는데, 이는 ''RET'' 유전자(GDNF 리간드족), ''ASCL1'' 유전자(ASCL1), ''DOK7'' 유전자(Dok-7),[3] ''ENOL2'' 유전자(에놀라제 2), ''SYP'' 유전자(시냅토피신), 그리고 각각 ''CHGA''와 ''CHGB'' 유전자에 의해 암호화되는 크로모그라닌 A 및 크로모그라닌 B 등이 해당된다.[20]
5. 진단
유방유두종의 진단은 주로 영상 검사와 임상 증상을 통해 이루어진다. 각 아형별로 나타나는 특징과 주로 사용되는 검사 방법은 다음과 같다.
- '''유방 촬영술''': 유방유두종 발견의 중요한 검사 방법이다.
- 유두상 상피내관암종(PDCIS)은 특별한 증상이 없는 경우가 많아, 정기적인 유방 촬영술에서 우연히 미세 석회화나 작은 덩어리(결절성 음영)로 발견된다.[4]
- 피막 유두상 암종(EPC) 역시 최근에는 증상 없이 정기 유방 촬영술에서 발견되는 사례가 늘고 있다.[13]
- 고형 유두상 암종(SPC)은 유방 촬영술에서 보통 경계가 명확하고 둥근 고형 종괴로 나타난다. 만약 암세포가 주변 조직으로 퍼진(침윤성) 경우에는 종괴의 경계가 불규칙하거나 주변 조직의 구조적 변형이 관찰될 수 있다.[3]
- 침윤성 유두상 암종(IPC)도 유방 촬영술에서 둥글거나, 타원형이거나, 여러 갈래로 나뉜 잎사귀 모양(엽상)의 덩어리로 나타날 수 있다.[1]
- '''초음파 검사''': 유방 촬영술과 함께 중요한 진단 도구이다.
- 특히 피막 유두상 암종(EPC)의 경우, 초음파 검사를 통해 내부에 액체 성분(낭성)을 포함할 수 있는 둥글거나 타원형의 경계가 뚜렷한 덩어리를 확인할 수 있다.[3][7]
- '''임상 증상 및 촉진''': 환자가 느끼는 증상이나 의사의 촉진을 통해 발견되기도 한다.
- 유두상 상피내관암종(PDCIS)은 대부분 증상이 없지만, 드물게 혈성 유두 분비물이 나타날 수 있다.[11]
- 피막 유두상 암종(EPC)은 주로 유두 주변의 색소 침착 부위(유륜) 아래에서 만져지는 덩어리로 나타나며,[2][3] 약 5~20%의 환자에게서 혈성 유두 분비물이 관찰된다.[5]
- 고형 유두상 암종(SPC)은 유륜 아래 또는 그 외 다른 부위에서도 발생할 수 있으며, 혈성 유두 분비물이 나타날 수 있다.[21]
- 침윤성 유두상 암종(IPC) 역시 혈성 유두 분비물이나 손으로 만져지는 덩어리가 주된 발견 계기가 된다.[1]
드물지만, 피막 유두상 암종(EPC)이나 고형 유두상 암종(SPC)의 경우, 처음 발견된 종양 외에도 인접한 겨드랑이 림프절이나 다른 먼 조직으로 전이된 상태로 진단되기도 한다.[2][20]
6. 치료 및 예후
유두상 상피내암종(PDCIS)은 주로 수술적 제거를 통해 관리된다. 이는 종양 세포의 핵 등급과 에스트로겐 수용체 발현이 동일한 상피내관암종의 치료 방식과 같다(상피내관암종의 치료 참조).[3] 핵 등급은 암세포의 핵이 정상 유방 세포의 핵과 얼마나 유사한지를 나타내며, 등급이 높을수록 핵 모양이 비정상적이고 종양 세포가 더 공격적인 경향을 보인다. PDCIS는 피막 형성 유두상 암종(EPC)과 유사한 장기 생존율을 보여 예후가 매우 좋은 편이다.[2]
피막 형성 유두상 암종(EPC)의 가장 일반적인 치료법은 모든 종양 조직을 제거하는 완전한 외과적 절제술이다.[2][3] 일부 연구에서 EPC 종양의 3~11.1%가 발병 시 인접한 겨드랑이 림프절로 전이된 것으로 나타나, 전이 여부를 확인하기 위해 감시 림프절 생검이 수술과 함께 시행되기도 한다. 전이가 확인되면 의료 영상 등을 통해 원격 전이 여부를 추가로 검사한다.[5] 그러나 상피내 EPC와 침윤성 EPC의 결과는 통계적으로 유사하며, 대부분의 연구에서는 EPC 종양을 임상적으로 상피내 유방암(관상피내암종 참조)으로 간주하고 관리한다.[3] 공격적인 양상을 보이는 EPC 종양(예: 광범위한 침윤, 고등급 특징과 삼중 음성[6])이나 원격 전이가 있는 경우, 보조적으로 화학 요법 및/또는 방사선 요법으로 치료하기도 하지만[2][15], 이러한 추가 치료의 효과에 대한 데이터는 아직 부족하다.[3] 호르몬 요법(타목시펜 또는 아로마타제 억제제 등[16])은 50세 미만 환자, 수술이 부적합한 환자, 재발 환자에게 1차 또는 보조 요법으로 사용될 수 있다.[5] 대만에서 49명의 EPC 환자를 대상으로 한 연구에서는 종괴 절제술(25명) 또는 유방 절제술(24명)을 시행했으며, 일부는 보조 방사선(7명), 화학(3명), 호르몬(19명) 요법을 받았다. 평균 47개월 추적 관찰 기간 동안 5명이 재발했고 2명은 원격 전이가 발생했지만, 연구 종료 시 47명은 질병 없이 생존했다. 이 연구는 보조 방사선 및 호르몬 요법이 EPC 환자 치료에 유용할 수 있음을 시사했다.[16] 전반적으로 EPC 종양은 상피내 유방암과 유사한 예후를 보이며, 10년 생존율은 거의 100%, 10년 무병 생존율은 약 91%에 달한다.[2]
고형 유두상 암종(SPC)에 대한 최상의 치료법은 아직 명확하게 정의되지 않았다.[20][21] 발표된 265건의 SPC 사례 중 재발, 림프절 전이, 원격 전이가 일부 보고되었으나, 전이는 침윤성 SPC 환자에게서만 발생했다.[13] 2020년 기준으로 SPC로 인한 사망은 3건만 보고되었다.[12] 거의 모든 SPC 사례가 예후가 매우 좋기 때문에,[3][21] 종양의 침윤성 정도에 따라 유방 보존 수술(예: 종괴 절제술) 또는 유방 절제술로 치료한다. 전이성 등 더 공격적인 SPC 종양의 경우, 보조 화학 요법(예: 5-플루오로우라실 경구 제제[20]) 및/또는 호르몬 요법(타목시펜 또는 성선 자극 호르몬 방출 호르몬 작용제[20])이 사용될 수 있다.[21]
침윤성 유두상 암종(IPC)은 일반적으로 종괴 절제술 또는 유방 절제술과 함께 보조 방사선 요법, 화학 요법 및/또는 호르몬 요법으로 치료한다. 초기 단계(T1 또는 T2)이면서 전이가 없는 IPC 환자 10,485명을 대상으로 한 연구 결과, 종괴 절제술과 보조 방사선 치료를 병행한 경우 평균 생존 기간이 16.8년으로, 보조 치료 없는 종괴 절제술(14.2년)이나 유방 절제술(14.9년)보다 유의미하게 더 나은 결과를 보였다.[23] 더 진행된 단계(T3 또는 겨드랑이 림프절 전이 포함)의 IPC 환자 1,147명을 검토한 연구에서는 다양한 치료(종괴 절제술 68.2%, 유방 절제술 31.1%, 보조 방사선 치료 57.3%, 보조 화학 요법 16.1%, 내분비 요법 64.0%)를 받았으며, 전체 평균 5년 생존율은 71.4%였다. 이 연구에서는 낮은 등급의 질병을 앓거나 보조 방사선 치료를 받은 경우 5년 생존율이 유의미하게 더 높았다.[1] IPC 종양에 대한 다양한 치료법의 효능을 명확히 하기 위해서는 추가적인 연구가 필요하다.[1][6]
참조
[1]
논문
Clinicopathologic Characteristics and Prognosis of Invasive Papillary Carcinoma of the Breast
null
2021-05
[2]
논문
Encapsulated Papillary Carcinoma: A Case Report and Review of the Literature
null
2021
[3]
논문
Papillary neoplasms of the breast including upgrade rates and management of intraductal papilloma without atypia diagnosed at core needle biopsy
null
2021-01
[4]
논문
Papillary lesions of the breast
null
2022-01
[5]
논문
Encapsulated papillary carcinoma of breast; a clinicopathological study of 25 cases and literature review with emphasis on high grade variant
null
2020-12
[6]
논문
Papillary Neoplasms of the Breast: Diagnostic Features and Molecular Insights
null
2022-03
[7]
논문
Papillary neoplasms of the breast-reviewing the spectrum
null
2021-06
[8]
논문
Solid Papillary Carcinoma and Encapsulated Papillary Carcinoma of the Breast: Clinical-Pathologic Features and Basement Membrane Studies of 50 Cases
null
2021
[9]
논문
Breast cancer with neuroendocrine differentiation: an update based on the latest WHO classification
null
2021-06
[10]
논문
Clinicopathologic analysis of solid papillary carcinoma of the breast and associated invasive carcinomas
null
2006-04
[11]
논문
Metastatic Prostate Cancer Synchronous with Male Breast Papillary Ductal Carcinoma in situ: Management Dilemma and Literature Review
null
2021
[12]
논문
Papillary Lesions of the Male Breast: A Study of 117 Cases and Brief Review of the Literature Demonstrate a Broad Clinicopathologic Spectrum
null
2020-01
[13]
논문
Breast carcinomas of low malignant potential
null
2022-01
[14]
논문
Micropapillary ductal carcinoma in situ of the breast: an inter-institutional study
null
2010-02
[15]
논문
Encapsulated papillary carcinoma of the breast: an invasive tumor with excellent prognosis
null
2011-08
[16]
논문
Encapsulated papillary carcinoma of the breast: A clinicopathological study of 49 cases
null
2018
[17]
논문
PI3K inhibitors: review and new strategies
null
2020-06
[18]
논문
Long non-coding RNA ROR recruits histone transmethylase MLL1 to up-regulate TIMP3 expression and promote breast cancer progression
null
2021-03
[19]
논문
3D Functional Genomics Screens Identify CREBBP as a Targetable Driver in Aggressive Triple-Negative Breast Cancer
null
2021-02
[20]
논문
Invasive solid papillary carcinoma with neuroendocrine differentiation of the breast: a case report and literature review
null
2020-06
[21]
논문
Solid papillary carcinoma of the breast
null
2022
[22]
논문
Invasive Papillary Carcinoma of the Breast: Clinicopathological Features and Hormone Receptor Profile
null
2021-02
[23]
논문
Prognostic Factors, Treatment, and Outcomes in Early Stage, Invasive Papillary Breast Cancer: A SEER Investigation of Less Aggressive Treatment in a Favorable Histology
null
2018-06
[24]
논문
Clinicopathologic Characteristics and Prognosis of Invasive Papillary Carcinoma of the Breast
null
2021-05
[25]
논문
Encapsulated Papillary Carcinoma: A Case Report and Review of the Literature
null
2021
[26]
논문
Papillary neoplasms of the breast including upgrade rates and management of intraductal papilloma without atypia diagnosed at core needle biopsy
null
2021-01
[27]
논문
Papillary lesions of the breast
null
2022-01
[28]
논문
Encapsulated papillary carcinoma of breast; a clinicopathological study of 25 cases and literature review with emphasis on high grade variant
null
2020-12
[29]
논문
Papillary Neoplasms of the Breast: Diagnostic Features and Molecular Insights
null
2022-03
[30]
논문
Papillary neoplasms of the breast-reviewing the spectrum
null
2021-06
[31]
논문
Solid Papillary Carcinoma and Encapsulated Papillary Carcinoma of the Breast: Clinical-Pathologic Features and Basement Membrane Studies of 50 Cases
null
2021
[32]
논문
Breast cancer with neuroendocrine differentiation: an update based on the latest WHO classification
null
2021-06
[33]
논문
Clinicopathologic analysis of solid papillary carcinoma of the breast and associated invasive carcinomas
null
2006-04
본 사이트는 AI가 위키백과와 뉴스 기사,정부 간행물,학술 논문등을 바탕으로 정보를 가공하여 제공하는 백과사전형 서비스입니다.
모든 문서는 AI에 의해 자동 생성되며, CC BY-SA 4.0 라이선스에 따라 이용할 수 있습니다.
하지만, 위키백과나 뉴스 기사 자체에 오류, 부정확한 정보, 또는 가짜 뉴스가 포함될 수 있으며, AI는 이러한 내용을 완벽하게 걸러내지 못할 수 있습니다.
따라서 제공되는 정보에 일부 오류나 편향이 있을 수 있으므로, 중요한 정보는 반드시 다른 출처를 통해 교차 검증하시기 바랍니다.
문의하기 : help@durumis.com